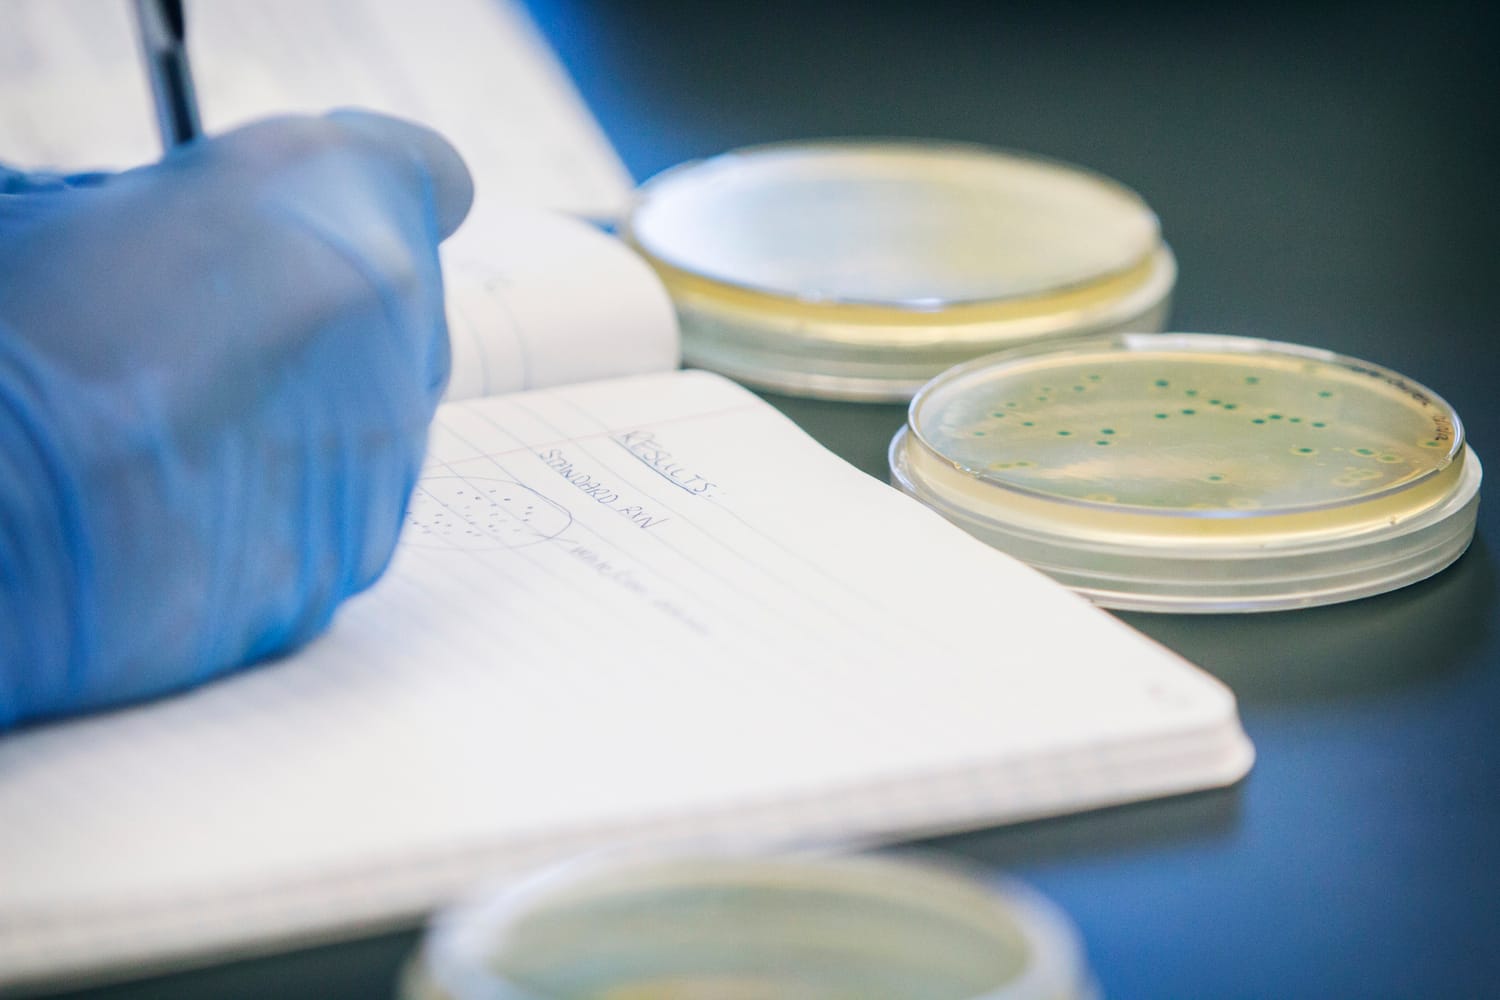
nauka2-foto-flickr-HagerstownCommunityCollege

Konkursi i projekti mogućnost za mlade naučnike da „isprobaju“ ideje

Ukoliko mladi naučnici u Srbiji žele da finansiraju sopstveno istraživanje, razviju prototip, gotov izum ili testiraju izvodljivost svoje ideje, jedini način za to je da budu angažovani na projektu ili da „prođu“ na nekom konkursu za finansiranje istraživanja, objašnjavaju profesori i studenti sa niškog PMF-a i Tehnološkog fakulteta u Leskovcu. Zato je aktuelni BASF Start-up Science konkurs dobra prilika za mlade inovatore.
Da je biti naučnik u Srbiji izuzetno teško, a biti madi naučnik u Srbiji gotovo jedino moguće ako je uključen u neki od projekata, napominje Violeta Mitić, načelnik Departmana za hemiju Prirodno-matematičkog fakulteta u Nišu.
Najčešće su to projekti Ministarstva prosvete, nauke i tehnološkog razvoja Republike Srbije i mali broj prijekata druge vrste. Mladi ljudi su u vrlo nezavidnom položaju jer nemaju rešeno finansijsko pitanje, ne vide perspektivu jer im je budućnost izvesna samo u periodu trajanja projekata. To je jedino vreme u kojem su sigurni u pogledu stalnih mesečnih primanja i kada lišeni brige o finansijskoj situaciji mogu da daju svoj istraživački maksimum – objašnjava Mitićeva.
Ističe da gotovo da nema generacije studenata hemije na PMF-u iz koje po neko, često najbolji ili među najboljima, ne nastavi rad van zemlje zbog boljih uslova.
Da je u inostranstvu više šansi za istraživače, potvrđuje i Marija Tasić, vanredni profesor Tehnološkog fakulteta u Leskovcu.
Generalno, nema mnogo konkursa u našoj zemlji za mlade naučnike, tek od nedavno su počeli da se raspisuju. Kada nemate razvijenu industiju, ideje i istraživanja završe samo na papirima – objašnjava Tasićeva.
Ona se nedavno vratila iz Brazila gde je radila na istraživanju bioetanola kao alternativnog goriva. Kaže da u toj zemlji privatne i državne agencije raspisuju konkurse za istraživanja, potom naučnici pišu projekte koje ocenjuje komisija, odnosno recezenti, a najbolje ideje dobijaju novac, odnosno istraživači dobijaju stipendiju.
Student doktorskih studija na Tehnološkom fakultetu Sandra Stamenković, koja je i stipendista Ministarstva prosvete, ističe da je sve više konkursa i šansi da se osvoje grantovi za istraživanje, ali da je najvažnije da mladi naučnici imaju dobru ideju. Ona se trenutno bavi sintetisanjem mikrobiološkog đubriva i veruje da su želja i znanje ključna kombinacija za uspeh.BASF dodeljuje 875.000 dinara najboljim studentima-inovatorima
Konkurs za bespovratno finansiranje naučno-istraživačkih projekata studenata svih godina osnovnih, master, doktorskih i specijalističkih studija, nedavno je raspisala nemačka hemijska kompanija BASF, pod pokroviteljstvom Kabineta ministra zaduženog za inovacije i tehnološki razvoj.
Ukupni novčani fond konkursa je 875.000 dinara, a osnovni uslov za učešće je da prijavljeni projekti doprinose rešavaju nekih od problema održivog razvoja, odnosno unapređuju postojeća rešenja.
Energetska efikasnost, mogućnosti za reciklažu različitih materijala, pijaća voda, čist vazduh, pronalaženje alternative za neobnovljive prirodne resurse zaokupljaju pažnju svuda u svetu i efikasno iznalaženje rešenja za ove probleme trasiraće dalji put čovečanstva u celini. Međutim, nedostatak kapitala čest je razlog zbog kog inovatori ne uspevaju da objave svoje patente, naučnici ne dovrše svoje radove, a dobre ideje ne budu realizovane. Na ovaj način želimo omogućiti da talenat i dobre ideje ne budu sputane, već naprotiv podstaknute kako bi dostigle svoj pun potencijal – istakao je Simon Franko, direktor kompanije BASF u Srbiji, Hrvatskoj i Sloveniji.
Da je potrebno više konkursa poput ovog ističe načelnica Deprtmana za hemiju niškog PMF-a.
Konkursi poput ovog nisu česti, te mladi hemičari nemaju mnogo mogućnosti da se uključe u istraživanja, a kamoli da ih sami osmisle i sprovedu. Razlog tome nije njihova nepripremljenost ili nedovoljna stručnost, već isključivo finansijski momenat. Bilo bi dobro kada bi ovakvih prilika bilo više i češće – objašnjava Violeta Mitić.
Zainteresovani studenti moći će da prijave svoja rešenja do 11. novembra, a najbolje ideje biće proglašene 20. decembra na javnoj odbrani.
Pravo učešća na konkursu imaju svi studenti prirodnih nauka nezavisno od nivoa studija, fakulteta ili univerziteta koji pohađaju. Takođe, nebitno je da li su njihovi projekti u početnoj ili poodmakloj fazi razvoja, ali je važno da prijavljeni radovi odgovaraju na neku od tri teme konkursa: urbano stanovanje, pametna energija i pametni gradovi.
Veliki “odliv mozgova” iz Srbije, odnosno odlazak velikog broja mladih i obrazovanih ljudi, predstavlja jedan od najvećih problema u Srbiji.
Južne vesti će se u narednom periodu baviti temama koje otvaraju nove šanse za zapošljavanje mladih ljudi, kako bi se sprečio njihov odlazak iz zemlje. Start ap programi, programi podrške finansirani od strane EU, samo su neke od mogućnosti kako bi se mladi zadržali u Srbiji i kako bi im se pružili kvalitetni uslovi rada.

Jelena Canić Milanović
Povezane teme
Slični tekstovi
Molimo vas da se u komentarima držite teme teksta. Redakcija Južnih vesti zadržava pravo da – ukoliko ih proceni kao neumesne – skrati ili ne objavi komentare koji sadrže osvrte na nečiju ličnost i privatan život, uvrede na račun autora teksta i/ili članova redakcije kao i bilo kakvu pretnju, uvredu, nepristojan rečnik, govor mržnje, rasne i nacionalne uvrede ili bilo kakav nezakonit sadržaj.
Komentare pisane verzalom i linkove na druge sajtove ne objavljujemo. Južne vesti nemaju nikakvu obavezu obrazlaganja odluka vezanih za komentare i njihovo objavljivanje.
Mišljenja iznešena u komentarima su privatno mišljenje autora komentara i ne odražavaju stavove redakcije Južnih vesti.
Smatra se da ste slanjem komentara potvrdili saglasnost sa gore navedenim pravilima.
Administratorima Južnih vesti se možete obratiti preko Kontakt stranice.

— Komentari
0